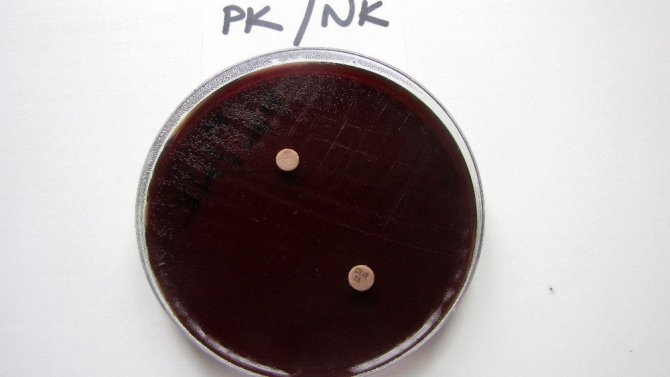

“Kekik kanser tedavisinde etkin rol oynuyor”
Deneysel Sağlık Bilimleri Araştırma Merkezi (DESAM) ve Eczacılık Fakültesi tarafından yapılan araştırmada Kuzey Kıbrıs’ta bulunan “Kekik, Çiğ Badem ile Molohiya’nın mide hastalıkları ile “kanser” teda...
Deneysel Sağlık Bilimleri Araştırma Merkezi (DESAM) ve Eczacılık Fakültesi tarafından yapılan araştırmada Kuzey Kıbrıs’ta bulunan “Kekik, Çiğ Badem ile Molohiya’nın mide hastalıkları ile “kanser” tedavisinde kullanılabileceği bulgularına ulaşıldı.
Yakın Doğu Üniversitesi Bilimsel Araştırma Projeleri Koordinasyon Birimi’nin Kıbrıs Adasına özgü bitkilerin Eczacılıkta Değerlendirilmesiyle ilgili destek verdiği üç projenin, mide hastalıkları ve kanser hastalıkların tedavisi üzerinde önemli bulgular gözlemlendi.
Yapılan çalışmalarda, Kuzey Kıbrıs’ta bulunan kekikten elde edilen yağın mide hastalıklarına neden olan bakteriyi öldürdüğünü, Badem Yağının kolon kanserini önleme ve metastazları engellemede etkili olduğunu, Molohiya bitkisinin ise kolon kanser hücrelerinde etkili olduğu belirtildi. Bitkilerin ayrıca ilaç kozmetik ürünlerinde de kullanılabileceği tespit edildi.
“Kekik mide hastalıklarına neden olan bakteriyi öldürücü etkiye sahip”
Yapılan çalışmalara göre, Kuzey Kıbrıs’ta yaygın olan Thymus capitatus (kekik) türünün yağının eczacılıkta değerlendirilme olanakları ve DESAM Laboratuarında yapılan analizlerle Helicobacter pylori üzerinde etkili olduğu sonucuna varıldığı belirtildi. Yapılan çalışmada, Kuzey Kıbrıs’ta bulunan bu kekik türünün gastrit ve duedonal ülserler, mide kanseri ve mide lenfomasında etken olarak bilinen Helicobacter pylori isimli bakteri üzerinde öldürücü etkisi olduğunu saptadı.
Çiğ badem ve Molohiya kolon kanseri önlenmesinde etkili
Sonuçları uluslararası Pharmaceutical Biology dergisinde yayınlanan “Kuzey Kıbrıs Çiğ Bademlerinin Eczacılıkta Değerlendirilmesi” projesinde de yapılan analiz ve değerlendirmelerde ‘Yedidalga Köyü’ kavrulmamış iç bademlerinden elde edilen badem yağının kolon kanserini önlediğini ve metastazları engellemede etkili olduğunu saptandı.
Yakın Doğu Üniversitesi Deneysel Sağlık Bilimleri Araştırma Merkezi (DESAM) ve Manisa Celal Bayar Üniversitesi işbirliği ile gerçekleştirilen bir diğer çalışmada ise Kıbrıs’a özgü Molohiya bitkisinin kolon kanseri hücrelerinde etkili olduğu belirlendi. Kıbrıs’ta yaygın olarak yetişen ve tüketilen Corchorus olitorius L. (Molohiya) bitki ekstraktının, primer ve metastatik kolon kanser türünde de anti-kanser etki gösterdiği, özellikle başka organlara da sıçrayabilen metastatik kanser hücrelerinde etkili olduğu saptandı. Araştırma sonuçları, Molohiya’nın potansiyel anti-kanser etkilerinin olduğunu ve ilerleyen yıllarda kolon kanseri tedavisinde potansiyel bir ilaç olarak kullanılabileceğini araştırma sonuçlarında öngörüldü.
Kıbrıs’a özgü bitkilerin korunması ve ekonomik olarak değerlendirilmesine yönelik önemli veriler elde edildi.
Kıbrıs’a özgü bitkiler üzerinde yapılan çalışmalar raporlaştırılarak ileriye dönük çalışmalarda kullanılmak üzere Sağlık ve Tarım Bakanlığı’na sunulacak. Kıbrıs’ın doğasında yetişen bitkilerin tarımının yapılıp endüstri haline getirilerek önünün açılmasını hedefleyen çalışmalarda hem öğrencilerin eğitimi için hem de geleneksel ve tamamlayıcı tıp tedavilerinde materyal sağlamada etkin bir rol oynayabilecekleri ifade edildi.

Türkçe karakter kullanılmayan ve büyük harflerle yazılmış yorumlar onaylanmamaktadır.